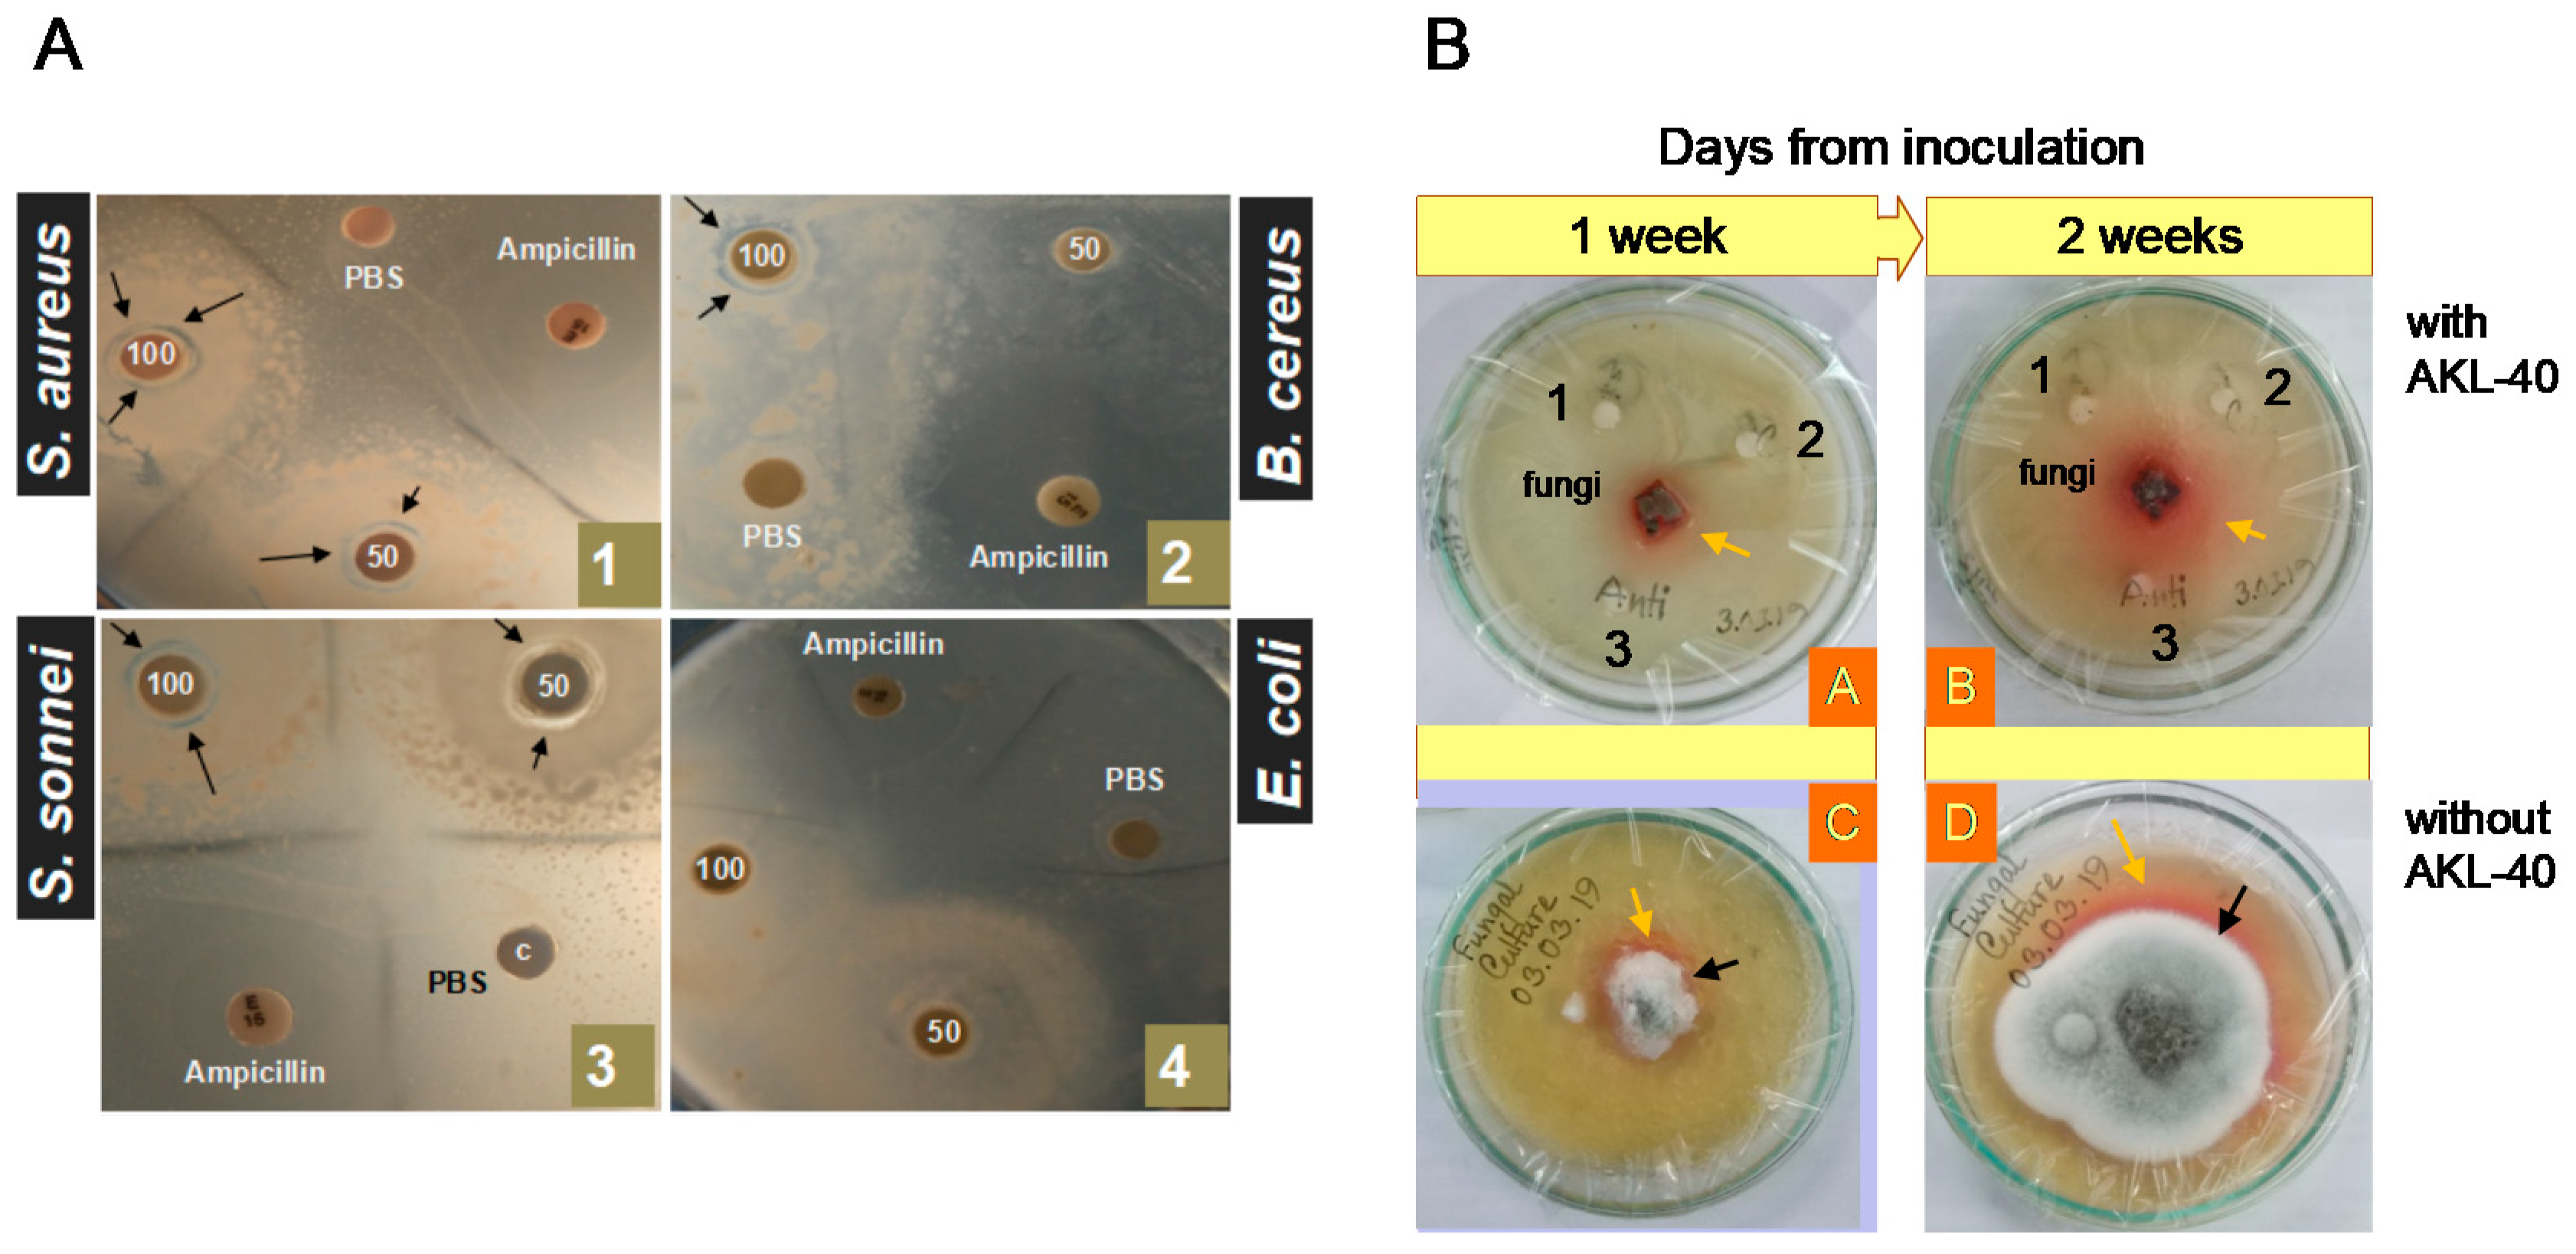
Marinedrugs 19 00394 g006 Marinedrugs 19 00394 g006

Antiproliferative and Antimicrobial Potentials of a Lectin from Aplysia kurodai (Sea Hare) Eggs
Abstract
1. Introduction
2. Results
2.1. Purification, Confirmation of the Molecular Mass and Hemagglutination Activity of Aplysia kurodai Egg Lectin (AKL-40)
2.2. N-Terminal Amino Acid Sequence of AKL-40
2.3. Toxicity of AKL-40 against Brine Shrimp Artemia nauplii
2.4. In Vivo Anticancer Activity of AKL-40 against Ehrlich Ascites Carcinoma Cells, Their Morphological Changes, and Expression of Apoptosis-Related Genes
2.5. In Vitro Anticancer Activity of AKL-40 against Different Cancer Cells and Activation of Signal Transduction Molecules
2.6. Antimicrobial Activity of AKL-40
3. Discussion
4. Materials and Methods
4.1. Preparation of the Crude Extract
4.2. Purification of the Lectin
4.3. Determination of N-Terminal Partial Amino Acid Sequence of AKL-40
4.4. Determination of the Toxicity of AKL-40 by Brine Shrimp Nauplii Lethality Assay
4.5. In Vivo Anticancer Activity of AKL-40 against Ehrlich Ascites Carcinoma Cells Grown in Swiss Albino Mice
4.6. Morphological Observation of AKL-40 Treated EAC Cells by Fluorescence Microscope
4.7. RNA Isolation and Checking the Expression of Apoptosis-Related Genes from Ehrlich Ascites Carcinoma Cells
4.8. Determination of Cytotoxic Activity of AKL-40 against Cancer Cell Lines and Detection of Activated Signal Transduction Molecules
4.9. Determination of the Minimum Agglutination Concentration of EAC and U937 Cells by AKL-40
4.10. Anticancer Activity of AKL-40 in Vitro against U937 and Ehrlich Ascites Carcinoma Cells
4.11. Bactericidal Activity of AKL against Pathogenic Bacteria
4.12. Antifungal Activity of AKL-40 against Talaromyces verruculosus
4.13. Statistical Analysis
5. Conclusions
Supplementary Materials
Author Contributions
Funding
Institutional Review Board Statement
Acknowledgments
Conflicts of Interest
References
- Fujii, Y.; Dohmae, N.; Takio, K.; Kawsar, S.M.A.; Matsumoto, R.; Hasan, I.; Koide, Y.; Kanaly, R.A.; Yasumitsu, H.; Ogawa, Y.; et al. A lectin from the mussel Mytilus galloprovincialis has a highly novel primary structure and induces glycan-mediated cytotoxicity of globotriaosylceramide-expressing lymphoma cells. J. Biol. Chem. 2012, 287, 44772–44783. [Google Scholar] [CrossRef] [PubMed]
- Hirabayashi, J.; Dutta, S.K.; Kasai, K. Novel galactose-binding proteins in Annelida. Characterization of 29-kDa tandem repeat-type lectins from the earthworm Lumbricus terrestris. J. Biol. Chem. 1998, 273, 14450–14460. [Google Scholar] [CrossRef] [PubMed]
- Wang, J.H.; Kong, J.; Li, W.; Molchanova, V.; Chikalovets, I.; Belogortseva, N.; Lukyanov, P.; Zheng, Y.T. A beta-galactose-specific lectin isolated from the marine worm Chaetopterus variopedatus possesses anti-HIV-1 activity. Comp. Biochem. Physiol. C Toxicol. Pharmacol. 2006, 142, 111–117. [Google Scholar] [CrossRef] [PubMed]
- Gowda, N.M.; Goswami, U.; Khan, M.I. Purification and characterization of a T-antigen specific lectin from the coelomic fluid of a marine invertebrate, sea cucumber (Holothuria scabra). Fish Shellfish Immunol. 2008, 24, 450–458. [Google Scholar] [CrossRef]
- Hasan, I.; Ozeki, Y. Histochemical localization of N-acetylhexosamine-binding lectin HOL-18 in Halichondria okadai (Japanese black sponge), and its antimicrobial and cytotoxic anticancer effects. Int. J. Biol. Macromol. 2019, 124, 819–827. [Google Scholar] [CrossRef]
- Ohtsubo, K.; Marth, J.D. Glycosylation in cellular mechanisms of health and disease. Cell 2006, 126, 855–867. [Google Scholar] [CrossRef]
- Pang, X.; Li, H.; Guan, F.; Li, X. Multiple Roles of Glycans in Hematological Malignancies. Front. Oncol. 2018, 8, 364. [Google Scholar] [CrossRef]
- Stowell, S.R.; Ju, T.; Cummings, R.D. Protein glycosylation in cancer. Annu. Rev. Pathol. 2015, 10, 473–510. [Google Scholar] [CrossRef] [PubMed]
- Powlesland, A.S.; Hitchen, P.G.; Parry, S.; Graham, S.A.; Barrio, M.M.; Elola, M.T.; Mordoh, J.; Dell, A.; Drickamer, K.; Taylor, M.E. Targeted glycoproteomic identification of cancer cell glycosylation. Glycobiology 2009, 19, 899–909. [Google Scholar] [CrossRef] [PubMed]
- Queiroz, A.F.S.; Silva, R.A.; Moura, R.M.; Dreyfuss, J.L.; Paredes-Gamero, E.J.; Souza, A.C.S.; Tersariol, I.L.S.; Santos, E.A.; Nader, H.B.; Justo, G.Z.; et al. Growth inhibitory activity of a novel lectin from Cliona varians against K562 human erythroleukemia cells. Cancer Chemother. Pharmacol. 2009, 63, 1023–1033. [Google Scholar] [CrossRef]
- Kawsar, S.M.A.; Matsumoto, R.; Fujii, Y.; Matsuoka, H.; Masuda, N.; Iwahara, C.; Yasumitsu, H.; Kanaly, R.A.; Sugawara, S.; Hosono, M.; et al. Cytotoxicity and glycan-binding profile of a D-galactose-binding lectin from the eggs of a Japanese sea hare (Aplysia kurodai). Protein J. 2011, 30, 509–519. [Google Scholar] [CrossRef]
- Chernikov, O.; Kuzmich, A.; Chikalovets, I.; Molchanova, V.; Hua, K.F. Lectin CGL from the sea mussel Crenomytilus grayanus induces Burkitt’s lymphoma cells death via interaction with surface glycan. Int. J. Biol. Macromol. 2017, 104, 508–514. [Google Scholar] [CrossRef]
- Zurga, S.; Nanut, M.P.; Kos, J.; Sabotic, J. Fungal lectin MpL enables entry of protein drugs into cancer cells and their subcellular targeting. Oncotarget 2017, 8, 26896–26910. [Google Scholar] [CrossRef] [PubMed][Green Version]
- Fujii, Y.; Sugawara, S.; Araki, D.; Kawano, T.; Tatsuta, T.; Takahashi, K.; Kawsar, S.M.; Matsumoto, R.; Kanaly, R.A.; Yasumitsu, H.; et al. MRP1 expressed on Burkitt’s lymphoma cells was depleted by catfish egg lectin through Gb3-glycosphingolipid and enhanced cytotoxic effect of drugs. Protein J. 2012, 31, 15–26. [Google Scholar] [CrossRef] [PubMed]
- Moura, R.M.; Queiroz, A.F.; Fook, J.M.; Dias, A.S.; Monteiro, N.K.; Ribeiro, J.K.; Moura, G.E.; Macedo, L.L.; Santos, E.A.; Sales, M.P. CvL, a lectin from the marine sponge Cliona varians: Isolation, characterization and its effects on pathogenic bacteria and Leishmania promastigotes. Comp. Biochem. Physiol. A Mol. Integr. Physiol. 2006, 145, 517–523. [Google Scholar] [CrossRef]
- Schroder, H.C.; Ushijima, H.; Krasko, A.; Gamulin, V.; Thakur, N.L.; Diehl-Seifert, B.; Muller, I.M.; Muller, W.E. Emergence and disappearance of an immune molecule, an antimicrobial lectin, in basal metazoa. A tachylectin-related protein in the sponge Suberitesdomuncula. J. Biol. Chem. 2003, 278, 32810–32817. [Google Scholar] [CrossRef] [PubMed]
- Frirdich, E.; Whitfield, C. Lipopolysaccharide inner core oligosaccharide structure and outer membrane stability in human pathogens belonging to the Enterobacteriaceae. J. Endotoxin Res. 2005, 11, 133–144. [Google Scholar] [CrossRef] [PubMed]
- Cox, A.D.; Li, J.; Richards, J.C. Identification and localization of glycine in the inner core lipopolysaccharide of Neisseria meningitidis. Eur. J. Biochem. 2002, 269, 4169–4175. [Google Scholar] [CrossRef]
- Lodowska, J.; Wolny, D.; Jaworska-Kik, M.; Kurkiewicz, S.; Dzierzewicz, Z.; Weglarz, L. The chemical composition of endotoxin isolated from intestinal strain of Desulfovibrio desulfuricans. Sci. World J. 2012, 2012, 647352. [Google Scholar] [CrossRef]
- Kamiya, H.; Shimizu, Y. A natural agglutinin inhibitable by d-galacturonic acid in the sea hare Aplysia eggs: Characterization and purification. Nippon. Suisan Gakk. 1981, 47, 255–259. [Google Scholar] [CrossRef]
- Kawsar, S.M.A.; Matsumoto, R.; Fujii, Y.; Yasumitsu, H.; Dogasaki, C.; Hosono, M.; Nitta, K.; Hamako, J.; Matsui, T.; Kojima, N.; et al. Purification and biochemical characterization of D-galactose binding lectin from Japanese sea hare (Aplysia kurodai) eggs. Biochemistry 2009, 74, 709–716. [Google Scholar] [CrossRef]
- Hasan, I.; Watanabe, M.; Ishizaki, N.; Sugita-Konishi, Y.; Kawakami, Y.; Suzuki, J.; Dogasaki, C.; Rajia, S.; Kawsar, S.M.A.; Koide, Y.; et al. A galactose-binding lectin isolated from Aplysia kurodai (sea hare) eggs inhibits streptolysin-induced hemolysis. Molecules 2014, 19, 13990–14003. [Google Scholar] [CrossRef] [PubMed]
- Gilboa-Garber, N.; Susswein, A.J.; Mizrahi, L.; Avichezer, D. Purification and characterization of the gonad lectin of Aplysia depilans. FEBS Lett. 1985, 181, 267–270. [Google Scholar] [CrossRef]
- Carneiro, R.F.; Torres, R.C.; Chaves, R.P.; de Vasconcelos, M.A.; de Sousa, B.L.; Goveia, A.C.; Arruda, F.V.; Matos, M.N.; Matthews-Cascon, H.; Freire, V.N.; et al. Purification, biochemical characterization, and amino acid sequence of a novel type of lectin from Aplysia dactylomela eggs with antibacterial/antibiofilm potential. Mar. Biotechnol. 2017, 19, 49–64. [Google Scholar] [CrossRef]
- Wilson, M.P.; Carrow, G.M.; Levitan, I.B. Modulation of growth of Aplysia neurons by an endogenous lectin. J. Neurobiol. 1992, 23, 739–750. [Google Scholar] [CrossRef]
- Motohashi, S.; Jimbo, M.; Naito, T.; Suzuki, T.; Sakai, R.; Kamiya, H. Isolation, amino acid sequences, and plausible functions of the galacturonic acid-binding egg lectin of the Sea hare Aplysia kurodai. Mar. Drugs. 2017, 15, 161. [Google Scholar] [CrossRef] [PubMed]
- Jridi, M.; Nasri, R.; Marzougui, Z.; Abdelhedi, O.; Hamdi, M.; Nasri, M. Characterization and assessment of antioxidant and antibacterial activities of sulfated polysaccharides extracted from cuttlefish skin and muscle. Int. J. Biol. Macromol. 2019, 123, 1221–1228. [Google Scholar] [CrossRef]
- Kawsar, S.M.A.; Aftabuddin, S.; Yasumitsu, H.; Ozeki, Y. The cytotoxic activity of two D-galactose-binding lectins purified from marine invertebrates. Arch. Biol. Sci. 2010, 62, 1027–1034. [Google Scholar] [CrossRef]
- Hasan, I.; Asaduzzaman, A.K.M.; Swarna, R.R.; Fujii, Y.; Ozeki, Y.; Uddin, M.B.; Kabir, S.R. MytiLec-1 shows glycan-dependent toxicity against brine shrimp Artemia and induces apoptotic death of Ehrlich ascites carcinoma cells in vivo. Mar Drugs. 2019, 17, 502. [Google Scholar] [CrossRef]
- Moura, R.M.; Melo, A.A.; Carneiro, R.F.; Rodrigues, C.R.; Delatorre, P.; Nascimento, K.S.; Saker-Sampaio, S.; Nagano, C.S.; Cavada, B.S.; Sampaio, A.H. Hemagglutinating/Hemolytic activities in extracts of marine invertebrates from the Brazilian coast and isolation of two lectins from the marine sponge Cliona varians and the sea cucumber Holothuria grisea. An. Acad. Bras. Cienc. 2015, 87, 973–984. [Google Scholar] [CrossRef][Green Version]
- Carneiro, R.F.; de Melo, A.A.; Nascimento, F.E.; Simplicio, C.A.; Nascimento, K.S.; Rocha, B.A.; Saker-Sampaio, S.; Moura, R.M.; Mota, S.S.; Cavada, B.S.; et al. Halilectin 1 (H-1) and Halilectin 2 (H-2): Two new lectins isolated from the marine sponge Haliclona caerulea. J. Mol. Recognit. 2013, 26, 51–58. [Google Scholar] [CrossRef]
- Rahman, M.S.; Alam, M.B.; Choi, Y.H.; Yoo, J.C. Anticancer activity and antioxidant potential of Aponogeton undulatus against Ehrlich ascites carcinoma cells in Swiss albino mice. Oncol. Lett. 2017, 14, 3169–3176. [Google Scholar] [CrossRef] [PubMed]
- Eckhardt, A.E.; Goldstein, I.J. Occurrence of alpha-D-galactosyl-containing glycoproteins on Ehrlich tumor cell membranes. Biochemistry 1983, 22, 5280–5289. [Google Scholar] [CrossRef]
- Sakakibara, F.; Kawauchi, H.; Takayanagi, G.; Ise, H. Egg lectin of Rana japonica and its receptor glycoprotein of Ehrlich tumor cells. Cancer Res. 1979, 39, 1347–1352. [Google Scholar]
- Rabelo, L.; Monteiro, N.; Serquiz, R.; Santos, P.; Oliveira, R.; Oliveira, A.; Rocha, H.; Morais, A.H.; Uchoa, A.; Santos, E. A lactose-binding lectin from the marine sponge Cinachyrellaapion (Cal) induces cell death in human cervical adenocarcinoma cells. Mar. Drugs. 2012, 10, 727–743. [Google Scholar] [CrossRef] [PubMed]
- Chaves, R.P.; Silva, S.R.D.; Neto, L.G.N.; Carneiro, R.F.; Silva, A.L.C.D.; Sampaio, A.H.; Sousa, B.L.D.; Cabral, M.G.; Videira, P.A.; Teixeira, E.H.; et al. Structural characterization of two isolectins from the marine red alga Solieria filiformis (Kützing) P.W. Gabrielson and their anticancer effect on MCF-7 breast cancer cells. Int. J. Biol. Macromol. 2018, 107, 1320–1329. [Google Scholar] [CrossRef]
- Wu, L.; Yang, X.; Duan, X.; Cui, L.; Li, G. Exogenous expression of marine lectins DlFBL and SpRBL induces cancer cell apoptosis possibly through PRMT5-E2F-1 pathway. Sci. Rep. 2014, 4, 4505. [Google Scholar] [CrossRef] [PubMed]
- Timoshenko, A.V. Towards molecular mechanisms regulating the expression of galectins in cancer cells under microenvironmental stress conditions. Cell Mol. Life Sci. 2015, 72, 4327–4340. [Google Scholar] [CrossRef]
- Cedeno-Laurent, F.; Dimitroff, C.J. Galectins and their ligands: Negative regulators of anti-tumor immunity. Glycoconj. J. 2012, 29, 619–625. [Google Scholar] [CrossRef]
- Chanput, W.; Peters, V.; Wichers, H. THP-1 and U937 Cells. In The Impact of Food Bioactives on Health, 1st ed.; Verhoeckx, K., Cotter, P., Lopez-Exposito, I., Kleiveland, C., Lea, T., Mackie, A., Requena, T., Swiatecka, D., Wichers, H., Eds.; Springer International Publishing: New York, NY, USA, 2015; pp. 147–149. [Google Scholar] [CrossRef]
- Oda, T.; Iwaoka, J.; Komatsu, N.; Muramatsu, T. Involvement of N-acetylcysteine-sensitive pathways in ricin-induced apoptotic cell death in U937 cells. Biosci. Biotechnol. Biochem. 1999, 63, 341–348. [Google Scholar] [CrossRef]
- Hasegawa, N.; Kimura, Y.; Oda, T.; Komatsu, N.; Muramatsu, T. Isolated ricin B-chain-mediated apoptosis in U937 cells. Biosci. Biotechnol. Biochem. 2000, 64, 1422–1429. [Google Scholar] [CrossRef] [PubMed]
- Sahly, H.; Keisari, Y.; Crouch, E.; Sharon, N.; Ofek, I. Recognition of bacterial surface polysaccharides by lectins of the innate immune system and its contribution to defense against Infection: The case of pulmonary pathogens. Infect. Immun. 2008, 76, 1322–1332. [Google Scholar] [CrossRef] [PubMed]
- Hasan, I.; Gerdol, M.; Fujii, Y.; Rajia, S.; Koide, Y.; Yamamoto, D.; Kawsar, S.M.; Ozeki, Y. cDNA and gene structure of MytiLec-1, a bacteriostatic R-type lectin from the mediterranean mussel (Mytilus galloprovincialis). Mar Drugs. 2016, 14, 92. [Google Scholar] [CrossRef]
- Kawsar, S.M.A.; Mamun, S.M.A.; Rahman, M.S.; Yasumitsu, M.S.; Ozeki, Y. Growth inhibitory effects on microorganisms by a D-galactose-binding lectin purified from the sea hare (Aplysia kurodai) eggs: An in vitro study. Nat. Sci. 2010, 8, 82–89. [Google Scholar] [CrossRef]
- Huang, M.; Song, X.; Zhao, J.; Mu, C.; Wang, L.; Zhang, H.; Zhou, Z.; Liu, X.; Song, L. A C-type lectin (AiCTL-3) from bay scallop Argopecten irradians with mannose/galactose binding ability to bind various bacteria. Gene 2013, 531, 31–38. [Google Scholar] [CrossRef]
- Cheung, R.C.; Wong, J.H.; Pan, W.; Chan, Y.S.; Yin, C.; Dan, X.; Ng, T.B. Marine lectins and their medicinal applications. Appl. Microbiol. Biotechnol. 2015, 99, 3755–3773. [Google Scholar] [CrossRef]
- Benhamou, N. Ultrastructural study of galacturonic acid distribution in some pathogenic fungi using gold-complexed Aplysia depilans gonad lectin. Can. J. Microbiol. 1989, 35, 349–358. [Google Scholar] [CrossRef]
- Ruperez, P.; Moya, A.; Leal, J.A. Cell wall polysaccharides from Talaromyces species. Arch. Microbiol. 1986, 146, 250–255. [Google Scholar] [CrossRef]
- Iijima, R.; Kisugi, J.; Yamazaki, M. Antifungal activity of Aplysianin E, a cytotoxic protein of sea hare (Aplysia kurodai) eggs. Dev. Comp. Immunol. 1995, 19, 13–19. [Google Scholar] [CrossRef] [PubMed]
- Chikalovets, I.V.; Chernikov, O.V.; Pivkin, M.V.; Molchanova, V.I.; Litovchenko, A.P.; Li, W.; Lukyanov, P.A. A lectin with antifungal activity from the mussel Crenomytilus grayanus. Fish Shellfish Immunol. 2015, 42, 503–507. [Google Scholar] [CrossRef] [PubMed]
- Gomes, B.S.; Siqueira, A.B.S.; Maia, R.C.C.; Giampaoli, V.; Teixeira, E.H.; Arruda, F.V.S.; Nascimento, K.S.; Lima, A.N.; Souza-Motta, C.M.; Cavada, B.S.; et al. Antifungal activity of lectins against yeast of vaginal secretion. Braz. J. Microbiol. 2012, 43, 770–778. [Google Scholar] [CrossRef] [PubMed]
- Ituarte, S.; Brola, T.R.; Fernandez, P.E.; Mu, H.; Qiu, J.-W.; Heras, H.; Dreon, M.S. A lectin of a non-invasive apple snail as an egg defense against predation alters the rat gut morphophysiology. PLoS ONE 2018, 13, e0198361. [Google Scholar] [CrossRef]
- Laemmli, U.K. Cleavage of structural proteins during the assembly of the head of bacteriophage T4. Nature 1970, 227, 680–685. [Google Scholar] [CrossRef] [PubMed]
- Ozeki, Y.; Matsui, T.; Suzuki, M.; Titani, K. Amino acid sequence and molecular characterization of a D-galactoside-specific lectin purified from sea urchin (Anthocidaris crassispina) eggs. Biochemistry 1991, 30, 2391–2394. [Google Scholar] [CrossRef]
- Finney, D.J. Probit Analysis, 3rd ed.; Cambridge University Press: London, UK, 1971; p. 333. [Google Scholar]

| Primer | Forward | Reverse |
|---|---|---|
| p53 | 5′-GCGTCTTAGAGACAGTTGCCT-3′ | 5′-GGATAGGTCGGCGGTTCATGC-3′ |
| Bax | 5′-GGCCCACCAGCTCTGAGCAGA-3′ | 5′-GCCACGTGGGCGTCCCAAAGT-3′ |
| Bcl-XL | 5′-TTGGACAATGGACTGGTTGA-3′ | 5′-GTAGAGTGGATGGTCAGTG-3′ |
| GAPDH | 5′-GTGGAAGGACTCATGACCACAG-3′ | 5′-CTGGTGCTCAGTGTAGCCCAG-3′ |
Publisher’s Note: MDPI stays neutral with regard to jurisdictional claims in published maps and institutional affiliations. |
© 2021 by the authors. Licensee MDPI, Basel, Switzerland. This article is an open access article distributed under the terms and conditions of the Creative Commons Attribution (CC BY) license (https://creativecommons.org/licenses/by/4.0/).
Share and Cite
Swarna, R.R.; Asaduzzaman, A.K.M.; Kabir, S.R.; Arfin, N.; Kawsar, S.M.A.; Rajia, S.; Fujii, Y.; Ogawa, Y.; Hirashima, K.; Kobayashi, N.; et al. Antiproliferative and Antimicrobial Potentials of a Lectin from Aplysia kurodai (Sea Hare) Eggs. Mar. Drugs 2021, 19, 394. https://doi.org/10.3390/md19070394
Swarna RR, Asaduzzaman AKM, Kabir SR, Arfin N, Kawsar SMA, Rajia S, Fujii Y, Ogawa Y, Hirashima K, Kobayashi N, et al. Antiproliferative and Antimicrobial Potentials of a Lectin from Aplysia kurodai (Sea Hare) Eggs. Marine Drugs. 2021; 19(7):394. https://doi.org/10.3390/md19070394
Chicago/Turabian StyleSwarna, Rubaiya Rafique, A. K. M. Asaduzzaman, Syed Rashel Kabir, Nawshin Arfin, Sarkar M. A. Kawsar, Sultana Rajia, Yuki Fujii, Yukiko Ogawa, Keisuke Hirashima, Nanae Kobayashi, and et al. 2021. "Antiproliferative and Antimicrobial Potentials of a Lectin from Aplysia kurodai (Sea Hare) Eggs" Marine Drugs 19, no. 7: 394. https://doi.org/10.3390/md19070394
APA StyleSwarna, R. R., Asaduzzaman, A. K. M., Kabir, S. R., Arfin, N., Kawsar, S. M. A., Rajia, S., Fujii, Y., Ogawa, Y., Hirashima, K., Kobayashi, N., Yamada, M., Ozeki, Y., & Hasan, I. (2021). Antiproliferative and Antimicrobial Potentials of a Lectin from Aplysia kurodai (Sea Hare) Eggs. Marine Drugs, 19(7), 394. https://doi.org/10.3390/md19070394

